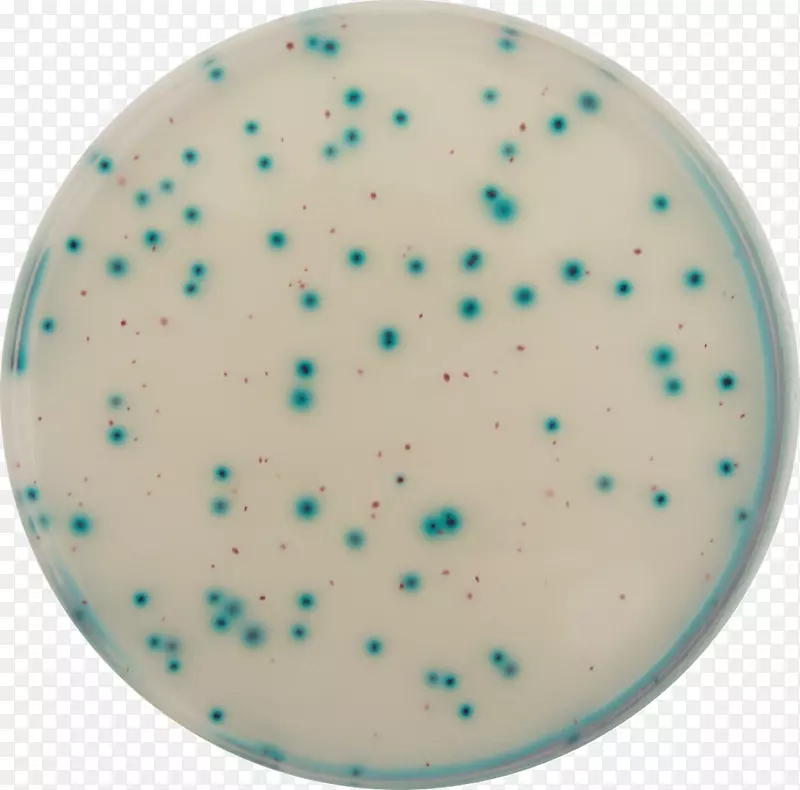
e���󳦸˾�����������-������

欢迎您 本站地址:
首页
图片素材
e。大肠杆菌生长培养基-图片素材分享-空若网

图片素材推荐-空若网

救援图标 斧头图标 水族

蓝色水色蔚蓝绿松石白色星星

线条 蓝色 水蓝

新月圈

美人鱼尾巴蓝色-装饰性蓝色美人鱼尾巴

产品设计字体品牌

采购产品假日装饰 绿松石 水

美食套装图标 厨房图标 咖啡机图标

商标字体-电脑

棒球帽-棒球帽

快乐排灯节 水 海报

材质浅绿色 青绿色 橙色

计算机图标.波形

绘画剪贴画-蓝色花

硬水溅落水波

放大镜 水蓝 蓝

化学元素google图片水-水波纹元素

绿松石圆

品牌标志字体-圆圈

雨伞 沙滩 浅绿色

卡通 水壶 茶壶

水彩画绿色水墨画

狗下载-面包饼干

水资源蓝天海壁纸葡萄酒湾度假村

水、纸、海、水

过去式设计

桌面壁纸品牌电脑字体电脑

金色色块
温馨提示 扫描下方二维码,访问手机版。